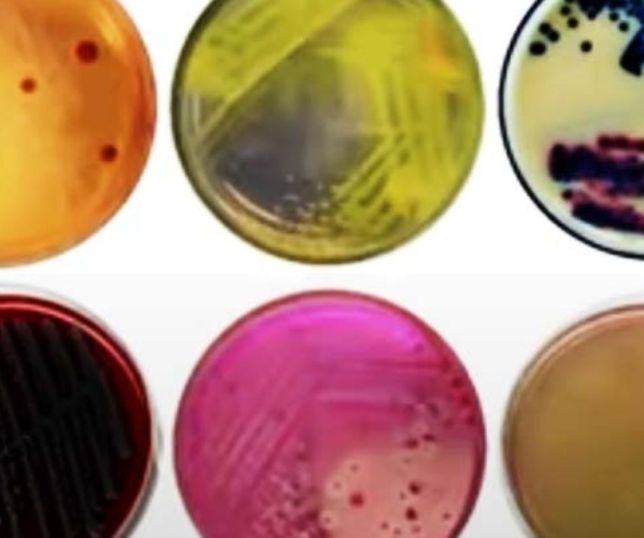

Programação acontece de 14 a 18 de outubro em Manaus, Tabatinga e Presidente Figueiredo
Incentivar meninas estudantes de escolas públicas a explorarem diferentes tipos de carreira na área da ciência, a exemplo de experiências de pesquisadoras da região, é o objetivo do evento “Fiocruz Amazônia: três décadas de história reveladas através das experiências e contribuições inspiradoras das mulheres na ciência” apoiado pelo Governo do Amazonas, por meio da Fundação de Amparo à Pesquisa do Estado do Amazonas (Fapeam).
O evento é fomentada via Programa de Apoio à Popularização da Ciência, Tecnologia e Inovação no Amazonas (POP CT&I), niciou hoje (14/10) e segue até esta sexta-feira (18/10), em Manaus, Tabatinga e Presidente Figueiredo (distantes a 1.108 e 117 quilômetros da capital, respectivamente), sob a coordenação da doutora em Genética e Biologia Molecular e atual diretora do Instituto Leônidas & Maria Deane (ILMD/Fiocruz Amazônia), Stefanie Costa Pinto Lopes.
“Nosso projeto visa através de diferentes abordagens apresentar a trajetória de cientistas mulheres de nossa instituição a partir de vídeos, rodas de conversa e jogos lúdicos”, explicou a coordenadora.
Veja também
Chuveiro e escova de dentes têm quantidade inacreditável de vírus, descobrem cientistas
SpaceX revoluciona exploração espacial com captura inédita de foguete
Para Stefanie Lopes, vivenciar a produção científica e tecnológica desde cedo contribui para a formação dessas jovens. A ideia é promover a igualdade de gênero, evidenciando o potencial das mulheres na ciência, para assim estimular as meninas a ocuparem os espaços acadêmicos.
“A expectativa é ressaltar a importância de investimento e dedicação do estado para o desenvolvimento da ciência, e atrair e permitir um ambiente mais inclusivo na carreira acadêmica”, destacou Stefanie.
A meta é também fortalecer a agenda da 21ª Semana Estadual de Ciência e Tecnologia (SNCT) que, em 2024, tem como tema: “Biomas do Brasil: diversidade, saberes e tecnologias sociais”. E o foco da programação do evento está nas trajetórias de pesquisadoras da Fiocruz Amazônia, que desenvolveram projetos centrados nas populações e particularidades da região.
Dentre as atividades, estão a exibição de vídeos documentários sobre mulheres em papel de protagonismo nos 30 anos do Instituto. Os episódios serão exibidos durante a SNCT/Fiocruz Amazônia e nas plataformas online.
A segunda atividade diz respeito ao Programa de Mentoria, que pretende conectar jovens mulheres ao universo científico. Os assuntos em discussão incluem escolhas de carreira, os desafios e oportunidades na área, e o desenvolvimento de habilidades.
A expectativa é que essa troca de conhecimentos sirva de inspiração para as estudantes de iniciação científica, de graduação e de pós-graduação.
Sobre o apoio da Fapeam para a realização do evento, Stefanie Lopes reforça a importância do investimento financeiro para a chegada de atividades como as do evento no interior do estado. “A Fapeam é uma parceira essencial para o desenvolvimento das pesquisas na Fiocruz Amazônia e tem sempre apoiado grandemente as atividades de popularização da ciência”, comentou.
PROGRAMAÇÃO
De 14 a 16 de outubro, serão realizadas rodas de conversa, apresentação de vídeos sobre a trajetória das mulheres na Ciência e oficinas de extração de DNA e de tipagem sanguínea, no Instituto Federal do Amazonas (Ifam), em Tabatinga. Projetos coordenados por pesquisadoras da instituição também estão entre os destaques, como pesquisas de Saúde Indígena e Qualidade da Água.
No dia 17 de outubro, na Escola Estadual de Tempo Integral Presidente Figueiredo, em Presidente Figueiredo, além das rodas de conversa, da apresentação de vídeos e de uma mostra científica de lâminas, os alunos terão acesso ao jogo educativo “Heliana, a menina que virou cientista” e a uma atividade lúdica ligada aos Objetivos do Desenvolvimento Sustentável (ODS).
E nos dias 17 e 18 de outubro, uma série de atividades serão realizadas no Espaço da Cidadania Ambiental (Ecam), do Manauara Shopping, no bairro Adrianópolis, zona centro-sul. Dentre elas uma mostra científica sobre a metamorfose dos insetos, exposição de trabalhos do ILMD/Fiocruz Amazônia em tecnologias sociais e uma visita guiada ao Buritizal do espaço, que será apresentada pela equipe a um grupo de estudantes do Ensino Fundamental II da Escola Municipal Santa Rosa II, localizada no bairro Tarumã, zona oeste da cidade.
POP CT&I
O POP CT&I apoia a realização de eventos de popularização da ciência, prioritariamente no interior do estado do Amazonas, por meio do financiamento da produção e distribuição de materiais educativos para democratizar a produção do conhecimento em Ciência, Tecnologia e Inovação (CT&I) e busca fortalecer a Semana Estadual de Ciência e Tecnologia e a Política Pública de CT&I do Amazonas.
EVENTOS CIENTÍFICOS DA FAPEAM
A agenda de eventos científicos do segundo semestre de 2024, apoiados pelo Governo do Amazonas, por meio da Fapeam, pode ser acessada em: https://www.fapeam.am.gov.br/programacao-de-eventos-cientificos-e-tecnologicos-apoiados-pela-fapeam-3/